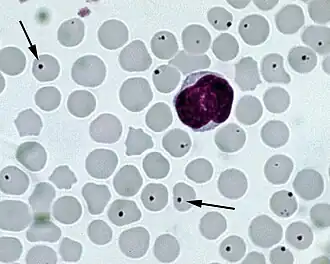
Description de cette image, également commentée ci-après

Anaplasma
| Domaine | Bacteria |
|---|---|
| Phylum | Pseudomonadota |
| Classe | Alphaproteobacteria |
| Ordre | Rickettsiales |
| Famille | Ehrlichiaceae |
Anaplasma est un genre de très petites bactéries intracellulaires à Gram négatif, proches des genres Ehrlichia et Wolbachia au sein de la famille des Ehrlichiaceae (anc. Anaplasmataceae). Elles se trouvent dans les plaquettes sanguines et provoquent des anaplasmoses. La maladie se rencontre principalement dans les zones tropicales[1].
Cycle de vie
Les Anaplasma ont besoin d'un hôte intermédiaire, une tique, (eg. Dermacentor) pour parvenir à maturité et des mouches comme vecteurs de transmission[1].
Anaplasmoses
Une des principales conséquences de l'infection des plaquettes par anaplasmes est une anémie hémolytique, due aux dommages subis par les cellules sanguines[1].
Liste d'espèces
Selon la LPSN (7 avril 2025)[2] ce genre comprend les espèces suivantes :
- Anaplasma caudatum (ex Kreier & Ristic 1963) Ristic & Kreier 1984
- Anaplasma centrale (ex Theiler 1911) Ristic & Kreier 1984
- Anaplasma marginale Theiler 1910 – espèce type
- Anaplasma ovis Lestoquard 1924
- Anaplasma phagocytophilum corrig. (Foggie 1949) Dumler et al. 2001
Espèces
Les espèces suivantes présentent un intérêt pour le vétérinaire :
- A. marginale et A. centrale pour le bétail ;
- A. mesaeterum et A. ovis pour les moutons et les chèvres[1] ;
- A. phagocytophilum pour les chiens, les chats et les chevaux (voir Human granulocytic anaplasmosis).
L'espèce Anaplasma sparouinense est responsable d'une zoonose rare, l’anaplasmose de Sparouine, connue uniquement en Guyane[3],[4]. Cette maladie a été découverte à la suite de l’infection d’un orpailleur vivant au cœur de la forêt tropicale humide. L’infection de ses globules rouges par Anaplasma sparouinense a entraîné une dégradation sévère de son état de santé et a nécessité son hospitalisation[4]. Des souches d'Anaplasma génétiquement proches circulent parmi les tiques et des mammifères d’Amérique du Sud qui pourraient constituer les réservoirs naturels de l’infection[4].
Génomes
Les génomes d'au moins trois espèces différentes dAnaplasma ont été séquencés[5]. Ces génomes sont d'environ 1.1 à 1.2 MB en taille et encodent de 925 à 1 335 protéines.
Voir aussi
- Piroplasmose
- Ehrlichiose
- Anaplasmose humaine
- Anaplasma phagocytophilum
- Anaplasma platys
- Anaplasmosis
Références
- (en) Cet article est partiellement ou en totalité issu de l’article de Wikipédia en anglais intitulé « Anaplasma » (voir la liste des auteurs).
- 1 2 3 4 Anaplasmas Publié par WikiVet, consulté le 10 octobre 2011.
- ↑ List of Prokaryotic names with Standing in Nomenclature (LPSN), consulté le 7 avril 2025.
- ↑ « L’anaplasmose de Sparouine, une nouvelle zoonose transmise par les tiques découverte en Guyane | INEE », sur www.inee.cnrs.fr (consulté le )
- 1 2 3 (en-US) Olivier Duron, Rachid Koual, Lise Musset et Marie Buysse, « Novel Chronic Anaplasmosis in Splenectomized Patient, Amazon Rainforest », Emerging Infectious Diseases journal, CDC, vol. 28, no 8, (DOI 10.3201/eid2808.212425, lire en ligne, consulté le )
- ↑ Anaplasma genomes in the JGI genome browser
Liens externes
- (en) MeSH Anaplasma.
- Anaplasma Genome Projects (de Genomes OnLine Database).
- Comparative Analysis of Anaplasma Genomes (à DOE's IMG system).
- Portail de la biologie cellulaire et moléculaire
- Portail de la microbiologie